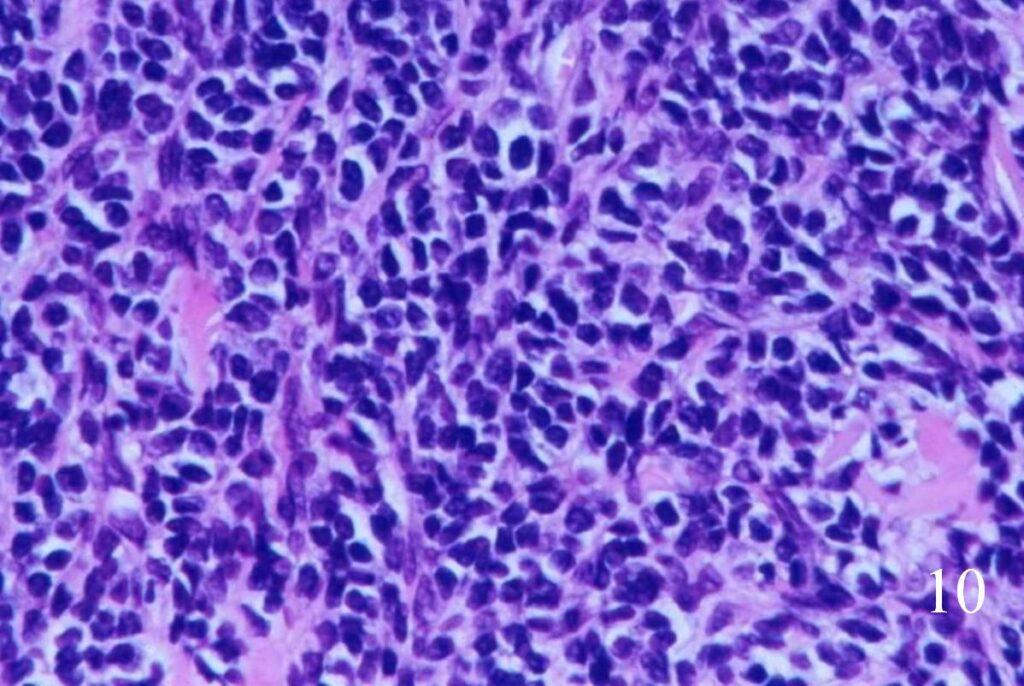

GENERAL INFORMATION
Extraskeletal chondrosarcoma is a rare cancerous soft tissue tumor. It is a cartilaginous producing spindle cell tumor (sarcoma) that occurs in the soft tissues as opposed to the more typical site in bone. Represents up to 2% of all soft tissue sarcomas and close to 1% of all chondrosarcomas. There are essentially two types of extraskeletal chondrosarcomas: extraskeletal myxoid chondrosarcoma and extraskeletal mesenchymal chondrosarcoma.
CLINICAL DATA
• It’s a rare malignant entity
• There are two varieties: Extrskeletal Myxoid Chondrosarcoma and Extraskeletal Mesenchymal chondrosarcoma
• Extraskeletal myxoid chondrosarcoma
• Frequently affects extremities
• Thigh —->most common
• Usually arises around the fifth decade of life
• Extraskeletal mesenchymal chondrosarcoma
• Predilection for
• head-neck,
• meninges,
• orbit and brain
• But also seen in thigh and other extremities.
• Preference for younger age group.
Differential diagnosis
• Synovial sarcoma
• Malignant fibrous histiocytoma
• Extraskeletal osteosarcoma
• Myositis ossificans
• Myxoma
• Myxoid Liposarcoma
CLINICAL PRESENTATION
Signs/Symptoms
• Presence of mass that is usually painless
• Depends on location
• Intracranial mass—->Blurred vision
Prevalence
• Rare entity
• Moderate predilection for male
• All ages, most common in older adults
• Myxoid chondrosarcoma
• Very unusual in children and adolescents (average age of patients 50 years old)
Sites
• Myxoid chondrosarcoma
• Extremities—–>usually lower (70%)
• Usually deep soft tissue
• Mesenchymal chondrosarcoma
• Meninges, orbit, neck, spine, lower extremities
• Other sites
RADIOGRAPHIC PRESENTATION
Extraskeletal Myxoid Chondrosarcoma
X-ray (Fig. 1-2)
• Soft tissue mass
• No calcification or bone formation present
CT
• Occasional osseous invasion
MRI
• Large, well demarcated often lobulated mass contained by pseudocapsule
• Associated with cysts and hemorrhage
• Intermediate and high signal intensity on T1W
• Heterogeneous lesion on T2W( predominantly high signal intensity)
• Heterogeneous enhancement of the mass postgadollinium.
Extraskeletal Mesenchymal Chondrosarcoma
X-ray
• Soft tissue mass with some mineralization
CT
• 50-100% demonstrate some mineralization
MRI (Fig. 3-7)
• Shows lobulated soft tissue mass
• Signal intensity similar to that of skeletal muscle on T1W
• Heterogenous signal intensity greater than that of fat on T2W

Fig. 1

Fig. 2
Fig 1-2. AP X-ray and lat (Fig. 2) of left hip shows a nonspecific soft tissue mass.

Fig. 3

Fig. 4

Fig. 5

Fig. 6

Fig. 7
Fig. 3-7 Axial MRI of the lower extremity shows an extraskeletal soft tissue chondrosarcoma in different sequences with and without contrast (Fig. 3, 4, 5). Sagittal MRI (Fig. 6, 7) T1 with-without contrast demonstrates enhancement of the mass
PATHOLOGY
Gross
Extraskeletal Mesenchymal Chondrosarcoma
• Soft
• Visible or palpable areas of calcium or cartilage
• Hemorrhage and necrosis unusual
• Usually small
Extraskeletal Myxoid Chondrosarcoma
• Lobulation and nodularity can be seen grossly
• Cut surface
• Gelatinous
• Slimy
• Hemorrhage common
• Usually large
• ~7 cm Ø
• Due to deepness and lack of symptoms
Microscopic
Extraskeletal Mesenchymal Chondrosarcoma (Fig. 8-10)
• Abundant small round blue cells
• Undifferentiated
• Round to elongate or spindle nuclei
• May grow in sheets or nodules, surround by fibrous tissue
• Usually proliferate around narrow vessels and pericytic sinusoidal vessels
• Islands of cartilage, may be calcified or ossified
Extraskeletal Myxoid Chondrosarcoma (Fig. 11-12)
• Lobules of chondroid like cells surrounded by fibrous tissue
• Variable cellularity, more near periphery
• Myxoid matrix
• Cells arranged in chains from periphery toward center
• Recognition of myxoid chondrosarcoma
• Discernible cytoplasm
• Cells usually attached to one another (neither occurs in other myxoid lesions)
Immunohistochemistry
• Positive for:
• S100
• Leu7/CD57
• Lysozyme
• Glycogen
• Acid mucin
• Negative for
• Keratin

Fig. 8

Fig. 9
Fig. 10
Fig. 8-10 Low (Fig. 8) and high power (Fig. 9) magnification of a mesenchymal chondrosarcoma shows cartilaginous areas and a mesenchymal component.
Fig. 10. High power magnification of mesenchymal area shows an area of undifferentiated small round blue cells.
Fig. 11
Fig. 12
Fig. 11. Low power magnification of myxoid chondrosarcoma of soft tissue shows pseudolobulation with concentration of tumor cells around vascular spaces, cord like aggregates of tumor cells surrounded by abundant intercellular myxoid basophilic matrix.
Fig. 12 High power of extraskeletal myxoid chondrosarcoma shows the cells with uniform in size; ovoid in shape, arranged in cords with delicate architecture. Mitotic index is low.
PROGNOSIS
Biological Behavior
• May be of low, intermediate, or high grade
• Most commonly arise from bone
• May also arise from soft tissue or next to the bone
• Myxoid type: low malignancy, may recur late
• High metastatic rate (mesenchymal type)
• Metastases: lymph nodes, lung, viscera
• In higher grade tumors
• Metastases may occur from a few months after excision, until over 20 years after surgery
TREATMENT (Fig. 13-15)
Extraskeletal Myxoid Chondrosarcoma
• Wide excision
• Amputation if unresectable
• Adjuvant chemotherapy may be indicated
• Adjuvant radiation therapy often indicated with limb sparing surgery
Extraskeletal Mesenchymal Chondrosarcoma
• Wide resection
• Chemotherapy is usually recommended
• Radiation for positive or close margins in pelvis or spine

Fig. 13
Fig. 14
Fig. 15
Fig. 13-15 Intraoperative photographs of the patient with extraskeletal mesenchymal chondrosarcoma in popliteal fossa of the lower extremity that underwent a radical resection.